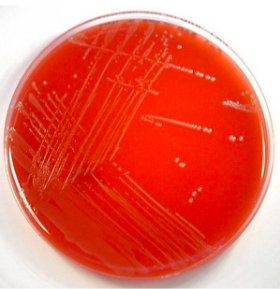

¿Cómo se clasifican?
cocos gram positivos
¿Cómo se acomodan?
pares o cadenas cortas

¿Qué forma tienen?
lenceolada
¿Cómo se clasifican? (lancefield)
grupo D
Hemolisis
gamma hemolíticos (No)
2 especies
E faecalis y E. faecium
3 características biológicas que las ayudan a colonizar y vivir
- 10-45 º C grados
- ph 4.6-9-9
- crecen en altas concentraciones de sal y en presencia de sales biliares
aerobios o anaerobios
ambas
¿Cómo producen enfermedad?
bacterias oportunistas (que le permita salir de su nicho original)
¿Qué toxinas producen?
no producen
Factores de patogenicidad (3)
- adhesinas de superficie (principal)
- forma biopelículas
- resistencia antibióticos comunes
¿Dónde coloniza?
Microbiota (toda la vida) colonizante colon (intestino grueso)
¿Cuál de las 2 especies es más común?
faecalis
Función de la Prueba de Bilis esculina
Diferenciar enterococcus (positiva) del streptococcus (negativa)

Prueba de Bilis esculina POSITIVA
La hidrólisis de la esculina reacciona con hierro y tiñe el medio de color marrón oscuro

¿A qué antibiótico es resistente?
optoquina
Su patogenia se relaciona con. . .
el cuidado hospitalario
Ejemplos de que su patogenicidad se relaciona con el cuidado hospitalario (2)
- uso de antibióticos de amplio espectro
- catéteres, sondas, dispositivos
Enfermedades clínicas (3)
- endocarditis
- infecciones de vías urinarias (cistitis y pielonefritis)
- infecciones peritoneales polimicrobianas
Endocarditis por enterococcus se asocia a. . .
catéteres
infecciones peritoneales polimicrobianas por enterococcus se asocia a. . .
secundaria a cirugía o traumatismo
infecciones de vías urinarias (cistitis y pielonefritis) por enterococcus se asocia a. . .
sonda urinaria


